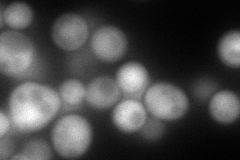
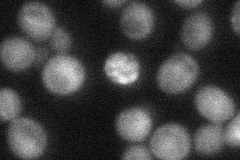
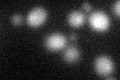

View description
Heme-binding protein involved in regulation of cytochrome P450 protein Erg11p; damage response protein, related to mammalian membrane progesterone receptors; mutations lead to defects in telomeres, mitochondria, and sterol synthesis
Localization:
Intensity:
Fold change:
Significance:
-
C’ GFP library in SD

below threshold13.62 -
N' NOP1pr-GFP in SD

cytosol,nucleus75.7076 -
N' TEF2pr-mCherry in SD
nucleus172.416 -
N' NATIVEpr-GFP in SD
cytosol36.3118 -
N' TEF2pr-VC and Cyto-VN in SD

#N/A0 -
C’ GFP library in SD+DTT
cytosol15.591.14No -
C’ GFP library in SD+H2O2

cytosol14.041.03No -
C’ GFP library in Starvation Media

cytosol16.781.23No -
C’ GFP library on the background of Pup2-DaMP

below threshold -
C’ GFP library on the background of CCT mutant

below threshold15.36731.12747No
